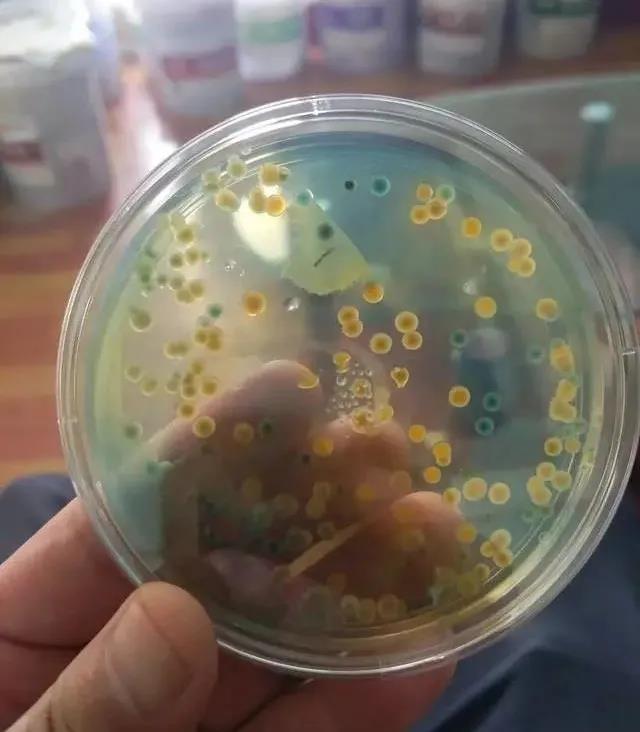

|
高密度精养虾塘,弧菌易大量爆发!组合高效防治方案 |
| 信息来源:泰安大同不凡生物工程有限公司 发布时间:2021-4-7 16:43:04 浏览量:1266 次 |
南美白对虾高密度精养,其中对于弧菌的关注颇多,目前养殖中常见的弧菌有溶藻弧菌、副溶血弧菌、哈维氏弧菌、霍乱弧菌等。文章将从高密度精养模式,如高位池、工厂化、车间养殖等不同养殖模式,与大家分享弧菌的防治措施。
水体弧菌含量过多易导致对虾发病;如华南地区的高位池出现大量排塘现象,主要就是弧菌的大量繁殖和爆发导致虾苗发病,空肠空胃、肝胰腺萎缩、偷死,排塘。 TCBS培养基检测水体弧菌含量与养殖对虾发病情况,一般绿弧菌达到1/3以上的80%发病,黄弧菌达到2/3以上如若不进行弧菌处理,易很快出现黄鳃、黄腿、肠道发红、水肠、肠道断节,粪便细长、打团、发粘、不成块,肝脏发红、发白、肿大等症状。 弧菌对肠道、肝胰脏的侵害较为严重,常引发对虾肠道糜烂、胃黏膜发炎、肠液积聚产生肠道积水、肝胰脏坏死、消化功能紊乱,表现为肠炎白便、空胃空胃、肝胰脏萎缩、偷死、长不大等现象。 对虾有死亡或体质偏弱时,TCBS培养基检测,一般都会表现出弧菌偏多情况,因为对虾体质偏弱,此时正值对虾免疫系统为薄弱的时候,弧菌易趁虚而入,进而滋生大量繁殖。
高密度精养模式弧菌大量爆发的原因 1、死藻、倒藻:水质变坏、变差后,调控不及时引起藻类大量死亡,藻类死亡沉淀积累在塘底发酵恶臭,弧菌在恶臭环境中大量繁殖爆发,及时发现水质变化并需作出调控; 2、排泄有机物质:粪便排放、剩饵、水生动物死尸等形成排泄有机物质长期积累过多,沉积在塘底后提供生长载体,弧菌大量繁殖; 3、有机肥:调水、肥水使用原生态有机肥,有机肥(鸡粪、有机发酵肥)原料制作过程弧菌可大量繁殖生长,有机肥(鸡粪、有机发酵肥)是弧菌生长的营养盐,直接使用将会把弧菌直接带入池塘,有机肥使用前先用生石灰把病菌消灭后再投入虾塘进行调水; 4、沸石粉、白云石粉:长期使用沸石粉、白云石粉把有害物质挤压在塘底,形成有害物质无法分解,导致氨氮、亚硝酸盐、硫化物等理化指标超并大量消耗底部溶解氧,给弧菌提供优良的载体和繁殖环境,同时在高温季节是存放在塘底里面的一颗定时炸弹。建议不依赖使用,在合适的处理方案中使用; 5、水源:养殖区域水质污染,含有大量弧菌,进水、加水过程中一起带入虾塘。 得出结论:弧菌的来源于死藻、倒藻、排泄物、有机肥、饲料、沸石粉、白云石粉等物质长期沉淀积累在塘底发酵,得不到及时分解引起理化指标增高大量消耗底部溶解氧,厌氧菌在底部环境脏、恶臭、差等情况下大量繁殖生长并感染虾体形成的病变现象。
南美白对虾高密度精养弧菌防控措施 养殖对虾和养殖水体是一个有机整体,所以处理水质的同时一定不要忽略对虾本身,对虾体质好,抗病力就强,遭弧菌侵袭的机率相对较少,反之则多,因此在处理水质环境时要同时内服保健。 高位池养虾弧菌防控:高位池养虾弧菌重在预防,注重水质和底质的养护,调藻养菌,换水排污,减少水体和底部的有机质底部的有机质,减少底部“氧债”,提高水体溶氧含量,对控制弧菌的繁殖都有较为明显的效果。加强对虾“肠、肝、胃、鳃”的养护,提高对虾自身免疫,不给弧菌可乘之机。 如若检测有弧菌大量繁殖,可如下进行处理: 1天:上午使用“水产多维”泼洒,提高对虾体质;下午使用“过硫酸氢钾复合盐”进行消毒处理; 第2天:上午再次使用“过硫酸氢钾复合盐”(高位池养虾弧菌大多附着在有机碎屑及底部的地膜和水管表面); 第3天:泼洒“乳酸菌”,补充有益菌群,低溶氧环境下能迅速形成有益菌群优势,控制弧菌;同时内服“杜仲叶提取物”+“乳酸菌”(使肠道内环境处于低pH值,控制清除肠道内弧菌)+“水产多维”,1天2餐,早晚各1餐,坚持拌料5~7天,加强内服保健,增强对虾体质,提高免疫。 工厂化、车间养虾弧菌防控:要加强弧菌检测、防控,定期消毒,防止弧菌感染,养殖中后期,约养殖35天左右以后,此时一般都是刚刚分苗结束,建议等分苗对虾摄食之后就可以7~10天进行消毒1次,建议使用“过硫酸氢钾复合盐” 或“二氧化氯”等相对较温和的消毒类产品,消毒12小时之后及时补充益生菌,可以补充“乳酸菌”,以便迅速形成有益菌群优势,防止弧菌迅速回长,可定期使用。
TCBS培养剂进行弧菌检测,切记不要一味纠结于弧菌 弧菌防控不能简单的靠消毒杀灭,消毒剂如同抗菌药一样,是不分种类,对所有菌群(包括有益菌和有害菌)统杀的,因此盲目消毒控制弧菌,不仅起不到效果,更易导致菌群失衡,破坏水体的菌相、藻相平衡,反而会加快弧菌的繁殖速度,这也是为什么好多人说今天刚刚消毒了,为什么弧菌又起来了的原因。 工厂化、车间养虾,多数是用菌养虾,这也符合“高产养菌”的理论,一个个几十平方养殖池就是一个大的微生物菌体微生态系统,此时对虾无论肠道、肝脏、吃食等,水体无论有机质、理化指标等都非常正常,如若此时进行一次消毒杀菌,就会破坏此时的微生态系统平衡,反而更易造成水质、对虾出现问题。弧菌繁殖速度超快,据调查显示一个弧菌分裂繁殖一代也只需要10分钟。建议感觉弧菌可能会超标时,在检测的同时,就先预防加以控制,因为很可能在检测结果还未出来的时间段里,弧菌就已经大量繁殖,造成对虾发病; 弧菌重在预防,弧菌几乎没办法被完全消灭,可以通过改变弧菌生活环境,达到控制弧菌数量的目的。 |